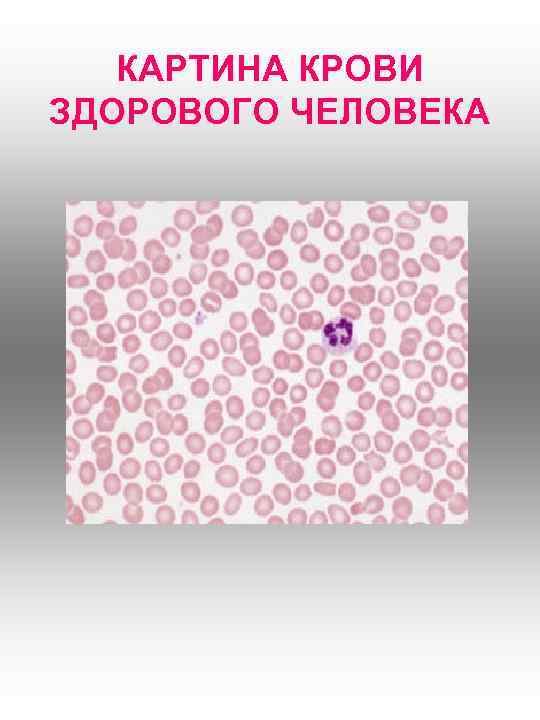
КАРТИНА КРОВИ ЗДОРОВОГО ЧЕЛОВЕКА
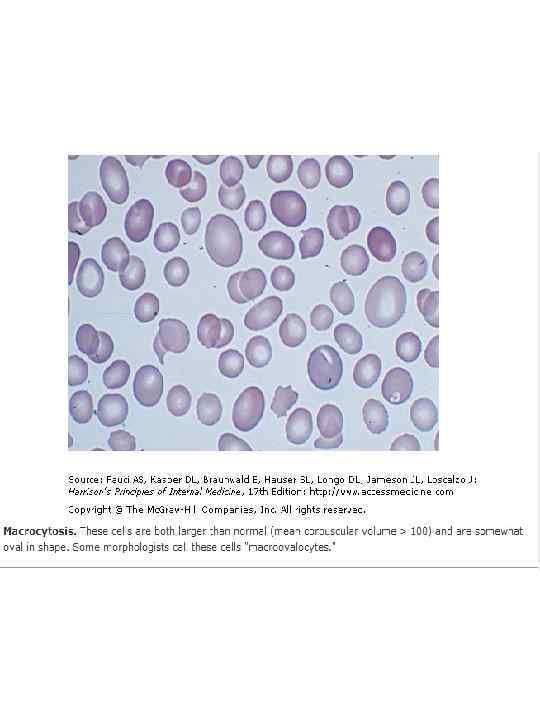
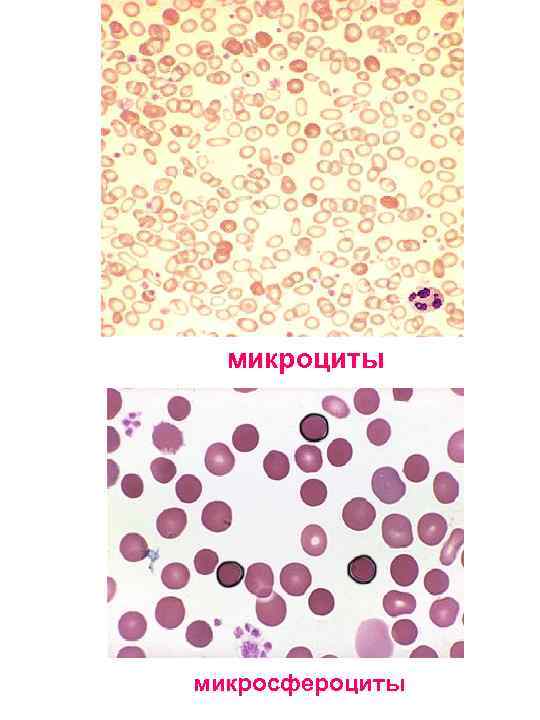
микроциты микросфероциты
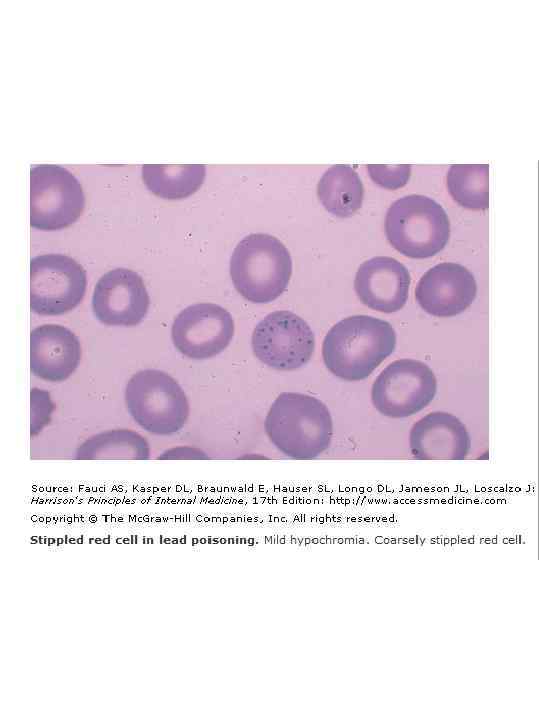
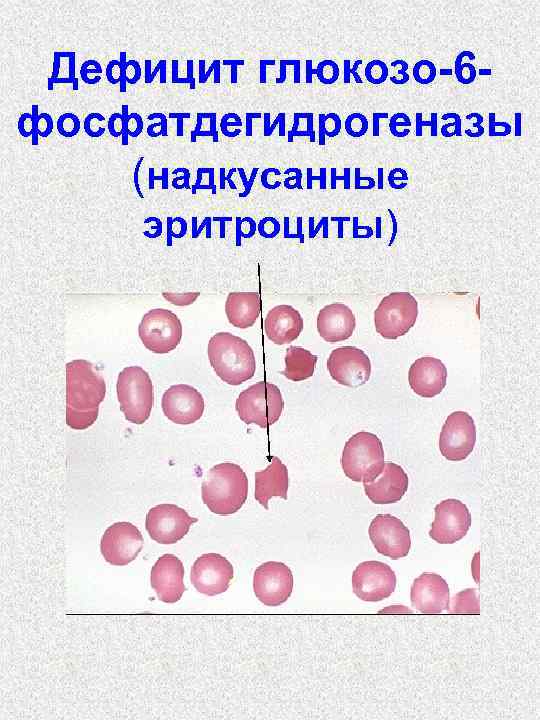
Дефицит глюкозо-6 фосфатдегидрогеназы (надкусанные эритроциты)
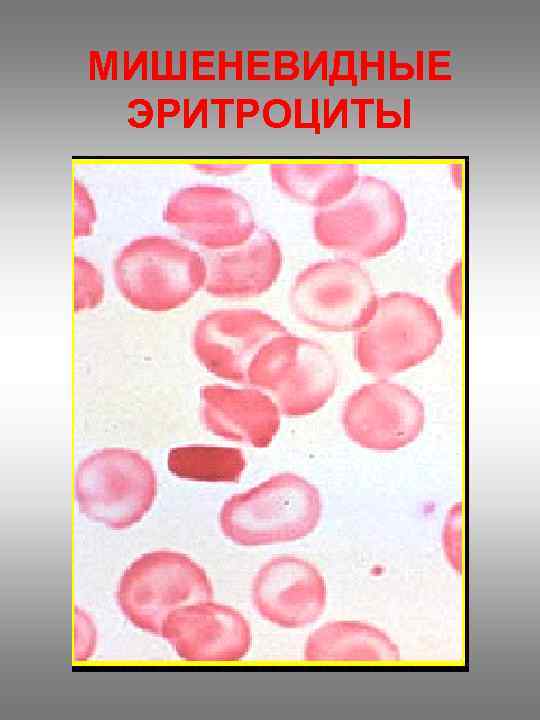
МИШЕНЕВИДНЫЕ ЭРИТРОЦИТЫ
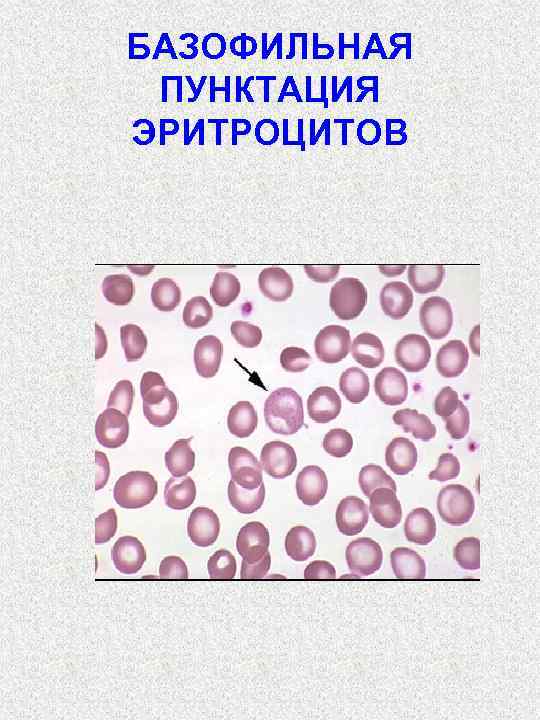
БАЗОФИЛЬНАЯ ПУНКТАЦИЯ ЭРИТРОЦИТОВ

• • АНЕМИИ Гемоглобин 130 -150 г/л муж 120 -140 г/л жен Эритроциты 4, 5 – 5, 5 × 10 12 /л муж 3, 7 – 4, 7 × 10 12 /л жен ЦП Hbх3 три первые цифры эритроцтов • Mean corpuscular volume (MCV) =77 -93 fl Гемотокрит л/л сод. эритр. /л Nano(n) = 10 -9, pico (p)= 10 -12, femto (f)= 10 -15

• Mean corpuscular hemoglobin (MCH) =27 -32 pg Hb / л эритр. /л • Mean corpuscular hemoglobin concentration (MCHC ) = 30 -35 g/dl Hb / л гематокрит л/л
КАРТИНА КРОВИ ЗДОРОВОГО ЧЕЛОВЕКА

Качественные изменения эритроцитов • Анизоцитоз – эритроциты разных размеров Эритроцит – 7, 2 – 8, 0 мкм Микроцит менее 7, 2 мкм микросфероцит Макроцит - более 8, 0 мкм

микроциты микросфероциты

Пойкилоцитоз – эритроциты разной формы:






Патологические включения üтельца Жолли üбазофильная пунктация эритроцитов üкольца Кабо üТельца Гейнца

РЕГЕНЕРАТИВНЫЕ ФОРМЫ ЭРИТРОЦИТОВ: полихроматофилы, ретикулоциты, нормобласты • КЛЕТКИ ПАТОЛОГИЧЕСКОЙ РЕГЕНЕРАЦИИ: • мегалобласты, эритроциты с тельцами Жолли и кольцами Кабо • ДЕГЕНЕРАТИВНЫЕ ФОРМЫ ЭРИТРОЦИТОВ: • Анизоцитоз, пойкилоцитоз, вакуализация цитоплазмы, тельца Гейнца


Принципы классификации анемий По этиологии l. Наследственные l Приобретенные

По патогенезу Ø А) вследствие кровопотери – постгеморрагические Ø Б) вследствие повышенного гемолиза эритроцитов – гемолитические Ø В) вследствие нарушения кровообразования дизэритропоэтические

ПО ЦВЕТОВОМУ ПОКАЗАТЕЛЮ (СТЕПЕНЬ НАСЫЩЕНИЯ ) ЭРИТРОЦИТОВ ГЕМОГЛОБИНОМ ГИПОХРОМНЫЕ ЦП - менее 0, 85 n НОРМОХРОМНЫЕ ЦП - 0, 85 – 1, 05 ГИПЕРХРОМНЫЕ ЦП - более 1, 05 n

По среднему диаметру эритроцитов n Микроцитарные менее 7, 2 мкм Нормоцитарные 7, 2 - 8, 0 мкм n Макроцитарные 8, 1 – 9, 5 мкм n Мегалоцитарные более 12 мкм

По способности костного мозга к регенерации Регенераторные (ретикулоциты 0, 2 - 1% и выше) Гипорегенераторные (ретикулоциты менее 0, 2 %) Арегенераторные (ретикулоциты 0%)

СХЕМА КРОВЕТВОРЕНИЯ

Картина крови острой постгеморрагической анемии (костномозговая стадия) ретикулоцитоз, полихроматофилия, появляются нормобласты; нейтрофильный лейкоцитоз с ядерным сдвигом влево



ОСТРАЯ ПОСТГЕМОРРАГИЧЕСКАЯ АНЕМИЯ • ПО ФУНКЦИОНАЛЬНОМУ СОСТОЯНИЮ КОСТНОГО МОЗГА • РЕГЕНЕРАТОРНАЯ • ПО ТИПУ КРОВЕТВОРЕНИЯНОРМОБЛАСТИЧЕСКАЯ • ПО ЦВЕТОВОМУ ПОКАЗАТЕЛЮ – НОРМО- ИЛИ ГИПОХРОМНАЯ • ПО СРЕДНЕМУ ДИАМЕТРУ ЭРИТРОЦИТОВ МАКРОЦИТАРНАЯ

Гемолитические анемии • Наследственные • Мембранопатии • Энзимопатии • гемоглобинопатии • Приобретенные

Мембрана эритроцита

Микросфероцитарная анемия Минковского. Шоффара


Картина крови микросфероцитарной анемии Нормальные эритроциты микросфероциты

Энзимопатии. Дефицит глюкозо-6 фосфатдегидрогеназы • Дефицит глюкозо-6 -ФДГ • Нарушение образования восстановленной формы глютатиона • Снижение антиоксидантной системы эритроцита • Гемолиз • Денатурация гемоглобина Тельца Гейнца
Дефицит глюкозо-6 фосфатдегидрогеназы (надкусанные эритроциты)

гемоглобин

Серповидноклеточная анемия

Эритроцит нормальный, серповидный

Цепи гемоглобина

Серповидно – клеточная анемия Световая микроскопия

Серповидно – клеточная анемия Растровая электронная микроскопия

Серповидные эритроциты

Серповидноклеточная анемия

Серповидно-клеточная анемия аваскулярный некроз в фалангах 3 пальца правой кисти

поражение левого тазобедренного сустава с деформацией головки бедренной кости

Талассемия

Талассемия. Череп «щеткой»

Талассемия
МИШЕНЕВИДНЫЕ ЭРИТРОЦИТЫ

ПРИОБРЕТЕННЫЕ ГЕМОЛИТИЧЕСКИЕ АНЕМИИ • ИММУННЫЕ • ТОКСИЧЕСКИЕ • ПРИ МЕХАНИЧЕСКОМ ПОВРЕЖДЕНИИ ЭРИТРОЦИТОВ

Иммунное повреждение эритроцитов (цитотоксический тип реакций)

Hemolytic disease of newborns

• Какие из указанных сочетаний могут вызвать гемолитическую болезнь новорожденных (4) • Мать cde, A (II); ребенок c. De, O (I) • Мать CDe, AB (IV); ребенок cd. E, O (I) • Мать cde, O (I); ребенок CDe, A(II) • Мать c. DE, O (I); ребенок Cde, A (II) • Мать Cde, B (III); ребенок c. De, B (III) • Что можно ввести резусотрицательной матери сразу после родов резусположительным ребенком с целью предупреждения ее иммунизации? (1) • Эритроциты с антигеном D • Эритроциты с антигеном d • Антитела против антигена D • Антитела против антигена d

КАРТИНА ПЕРИФЕРИЧЕСКОЙ КРОВИ • РЕТИКУЛОЦИТОЗ • ПОЛИХРОМАТОФИЛИЯ • ПОЯВЛЕНИЕ НОРМОБЛАСТОВ • ПОЙКИЛОЦИТОЗ • АНИЗОЦИТОЗ • ЭРИТРОЦИТЫ С БАЗОФИЛЬНОЙ ПУНКТАЦИЕЙ • НЕЙТРОФИЛЬНЫЙ ЛЕЙКОЦИТОЗ СО СДВИГОМ ВЛЕВО

1. ПОЛИХРОМАТОФИЛЫ 2. РЕТИКУЛОЦИТЫ 1 2
БАЗОФИЛЬНАЯ ПУНКТАЦИЯ ЭРИТРОЦИТОВ

1. ГИПЕРПЛАЗИЯ ЭРИТРОИДНОГО РОСТКА КРАСНОГО КОСТНОГО МОЗГА. 2. ПРОЛИФЕРАЦИЯ НОРМОБЛАСТОВ 1 2

ОСТРЫЕ ПРИОБРЕТЕННЫЕ ГЕМОЛИТИЧЕСКИЕ АНЕМИИ • ПО ФУНКЦИОНАЛЬНОМУ СОСТОЯНИЮ КОСТНОГО МОЗГА • РЕГЕНЕРАТОРНЫЕ • ПО ТИПУ КРОВЕТВОРЕНИЯ - НОРМОБЛАСТИЧЕСКИЕ • ПО ЦВЕТОВОМУ ПОКАЗАТЕЛЮ – • НОРМО- ИЛИ ГИПЕРХРОМНЫЕ • ПО СРЕДНЕМУ ДИАМЕТРУ ЭРИТРОЦИТОВ МАКРОЦИТАРНЫЕ

Железодефицитная анемия Всасывание железа в тонком кишечнике

Содержание гемосидерина в красном костном мозге: 1 - в норме 2 - при ЖДА 1 2



КАРТИНА КРОВИ ЖДА üГИПОХРОМИЯ ЭРИТРОЦИТОВ (АНУЛОЦИТЫ, ПЛАНОЦИТЫ), üПОЙКИЛОЦИТОЗ, АНИЗОЦИТОЗ (МИКРОЦИТЫ), üСКЛОННОСТЬ К ЛЕЙКОПЕНИИ

Признаки тканевого дефицита железа при ЖДА

ЖЕЛЕЗОДЕФИЦИТНЫЕ АНЕМИИ ü по ЦП – гипохромные ü По способности костного мозга к регенарации – гипорегенераторные ü По типу кроветворения – нормобластические ü по СДЭ – микроцитарные

Витамин в 12 – дефицитные анемии Витамина В 12 метилкобаламина дезоксиаденозилкобаламина

Типы кроветворения


Нормобласты и мегалобласты в красном костном мозге

метилкобаламина Нарушение синтеза ДНК Нарушение процессов деления и созревания эритроцитов Мегалобластический тип кроветворения Неэффективный эритропоэз Продолжительности жизни эритроцитов

Картина периферической крови при В 12 -дефицитной анемии • Анизоцитоз, пойкилоцитоз, гиперхромия эритроцитов, появление мегалоцитов и мегалобластов, эритроцитов с тельцами Жолли и кольцами Кабо • Лейкопения, появление полисегментированных гигантских нейтрофилов, тромбоцитопения

Гигантский палочкоядерный и гиперсегментированный нейтрофил

Нарушение синтеза ДНК • Нарушение пролиферации клеток ЖКТ • Атрофия слизистой желудка, кишечника, глоссит Хантера

Дезоксиаденозилкобаламина • Нарушение синтеза жирных кислот • Нарушение образования миелина • Фуникулярный миелоз (парестезии, нарушение походки, боль)

ВИТАМИН В 12 ДЕФИЦИТНАЯ АНЕМИЯ • ПО ТИПУ КРОВЕТВОРЕНИЯ -МЕГАЛОБЛАСТИЧЕСКАЯ • ПО ФУНКЦИИ КОСТНОГО МОЗГА – ГИПОРЕГЕНЕРАТОРНАЯ • ПО ЦВЕТОВОМУ ПОКАЗАТЕЛЮ – ГИПЕРХРОМНАЯ, • ПО СДЭ МЕГАЛОЦИТАРНАЯ

Апластическая анемия • Наследственная • Приобретенная • Патогенез: • Дефект гемопоэтических клеток • Нарушение системы кроветворного микроокружения • Иммунное повреждение кроветворных клеток



Красный костный мозг при апластической анемии

ЭТИОЛОГИЧЕСКИЕ ФАКТОРЫ ПОВРЕЖДЕНИЕ СТВОЛОВЫХ КЛЕТОК ПАНЦИТОПЕНИЯ: ЭРИТРОПЕНИЯ ЛЕЙКОПЕНИЯ ТРОМБОЦИТОПЕНИЯ ГИПОКСИЯ РЕЗИСТЕНТНОСТИ ЯЗВЕННО-НЕКРОТИЧЕСКИЕ ПРОЦЕССЫ КРОВОТОЧИВОСТЬ

Гипоапластическая анемия • ПО ТИПУ КРОВЕТВОРЕНИЯ -НОРМОБЛАСТИЧЕСКАЯ • ПО ФУНКЦИИ КОСТНОГО МОЗГА – АРЕГЕНЕРАТОРНАЯ • ПО ЦВЕТОВОМУ ПОКАЗАТЕЛЮ – НОРМОХРОМНАЯ, • ПО СДЭ НОРМОЦИТАРНАЯ